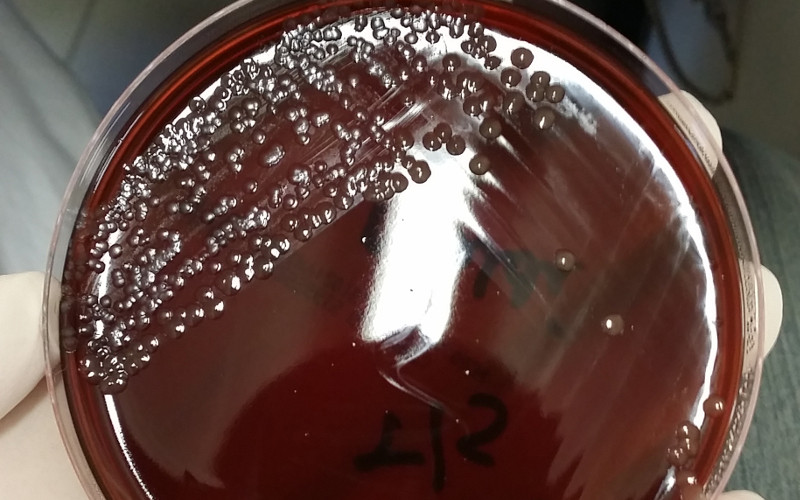
Cultivobacteriasenfermedad

Las bacterias multirresistentes matan a más de 35.000 personas al año en España
Esto representa, por ejemplo, 30 veces más que las muertes por accidentes en carretera, que fue de 1.200 en 2017.
Más de 35.000 personas con infecciones por bacterias multirresistentes mueren al año en España, según un estudio de la Sociedad Española de Enfermedades Infecciosas y Microbiología Clínica (SEIMC).
Este estudio epidemiológico ha estimado la mortalidad bruta a los 30 días del diagnóstico de la infección, y surge con el objetivo de conocer el impacto clínico real en una muestra representativa para facilitar la planificación de los recursos sanitarios.
los tres tipos de infección más común han sido las urinarias, las intraabdominales y las neumonías.
De mantenerse los datos del estudio a lo largo del año, el número de pacientes con infecciones por bacterias multirresistentes durante 2018 en España será de...

O Sergas desminte a existencia dunha epidemia bacteriolóxica no Cunqueiro
O Sergas desminte a existencia dunha epidemia bacteriolóxica no Cunqueiro





Escribe tu comentario